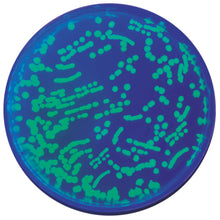
Load image into Gallery viewer, edvotek 323

Colony PCR represents a simple and easy way to determine whether cloning and transformation experiments were successful.
In this Edvotek experiment, students will use colony PCR to analyze bacteria transformed with pFluoroGreen. A single colony will be used as the DNA template for PCR. The resulting PCR sample will then be analyzed using agarose gel electrophoresis. If the bacteria have been transformed successfully, a PCR product representing the GFP gene will be produced. A bacterial housekeeping gene is amplified at the same time as a positive control. The presence of both bands is indicative of a successful transformation experiment.
This kit is intended for use in conjunction with Edvotek Transformation Kits 222, 223 or 303.
For 10 groups of students.
Time required: Set Up - 30 minutes | PCR - 2 hours or overnight | Electrophoresis - 45 minutes.
Kit includes: Instructions, PCR EdvoBeads™, Colony Primer Mix Concentrate, Control DNA Concentrate, Ampicillin, IPTG, EdvoQuick™ DNA Ladder, TE Buffer, BactoBeads™, ReadyPour™ Luria Broth Agar, Petri Dishes, , ampicillin, IPTG, ReadyPour™ Luria Broth Agar (sterile), UltraSpec-Agarose™, Electrophoresis Buffer (50X), 10X Gel Loading Solution, InstaStain® Ethidium Bromide, FlashBlue™ Liquid Stain, Petri Plates, Sterile Loops, Microcentrifuge & PCR Tubes & Wax Beads.
All you need: DNA Electrophoresis, Thermal Cycler, Micropipettes: 5-50 µl, UV or Blue Light Transilluminator, (3) Water Baths (if performing experiment without a Thermal Cycler), White Light Box (optional), Microcentrifuge, & Microwave or Hot plate.